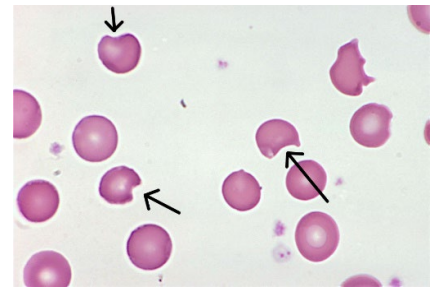

Proteins that maintain RBC shape
Spectrin
Ankyrin
Actin
Band 4.1
Proteins that function as high affinity glucose transport anchors for ABO antigens
Glycophorins (GPs)
What protein is responsible for RBC osmotic balance?
Anion exchange protein (Band 3)
Where is EPO synthesized during fetal development?
The developing liver, subsequently moving to the kidney (physiologic source of EPO at the time of delivery)
What can cause the liver to reactivate EPO production?
Hepatitis/liver cancer
What renal cells normally produce EPO?
Peritubular cells in the renal cortex -
Decreased blood Hb concentration (anemia) is experienced by the cortical cells as hypoxia - hypoxia inducible factor (HIF) alpha is a transcriptional reuglator that induces EPO transcription under hypoxic conditions
Increased oxygenation - specific prolyl hydroxylases will hydroxylate proline and asparagine residues in HIFα (undergoes ubiquination by the von Hippel-Lindau (VHL protein complex)

Most common etiology of familial erythrocytosis
LOF mutation in the VHL gene
(VHL ubiquinates HIFα and designates it for the proteosome complex)
Pt’s suffer from increased RBC production out of proportion to physiologic need

Single most common genetic cause of erythrocytosis
Hemoblogin distrubtion in adult
In the normal adult:
95 – 98% of Hb is hemoglobin A (HbA), made up of two α chains and two β chains (α2β2),
2-3% HbA2 (α2δ2), and
0.5-1.5% fetal hemoglobin (HbF) (α2γ2).

How are alpha/beta Hb subunits inherited?
Two α globin genes and one β globin gene are inherited from each parent
so that the normal α globin
genotype is αα/αα and the normal β globin genotype is β/β.
R (relaxed) Hb state
OxyHb
T (tense) Hb state
deoxyHb
2,3-BPG binds to positive residues on β subunit and stabilizes the tense state
Methemoglobin (MetHb)
Hb containing heme in which iron has been oxidized to ferric iron (Fe3+) and does not bind oxygen
Cytochrome b5 reductase is an enzyme that reverse heme iron oxidation
M-hemoglobins (M-Hb)
Congenital mutation in either the α-, β-, or γ-globin chains that stabilize the heme group in the ferric (3+) state
Pt’s w/ mutated γ-globin exhibit “neonatal cyanosis” that resolves as HbF production decreases
M-Hb patients will have normal ferroprotoporphyrin IX as the heme
group on the unmutated chains, which permits adequate oxygen delivery.
M-Hb patients are asymptomatic other than a cyanosis-like appearance when deoxyHb concentration is > 5%. There is no treatment required or necessary, and methylene blue is ineffective and can be toxic.
How do RBCs transport CO2?
Most of the CO2 from tissue capillaries is carried by Hb as bicarbonate (HCO3-) generated by RBC carbonic anhydrase
10% carried as a carbamino complex bound reversibly to globin chains
Hb catabolism
Macrophages recognize damaged RBCs in marrow, liver, spleen - phagocytose RBC
Hg undergoes oxidative degradation in the cytoplasm
Heme is oxidized to ferric protoporphyrin IX (hemin) - then metabolized by heme oxygenase (HOx)
Bilberdin is reduced to bilirubin by biliverdin reductase - transported to liver
HOx is rapidly induced by the presence of heme - results in the release of carbon monoxide, ferric iron (may be stored as ferritin or released into plasma bound to transferrin), and biliveridin
What is the Hb scavenger receptor?
CD163 expressed on the surface of macrophages - endocytose haptoglobin-Hb complex
Extravascular hemolysis
Hemolysis that occurs in the spleen or liver
Intramedullary hemolysis
Hemolysis that occurs in the marrow as a result of ineffective production of RBCs and late RBC precursors that undergo degradation before they are released into circulation (ineffective erythropoiesis)
What binds heme released by extravascular/intramedullary hemolysis?
Hemopexin - gets taken up by the hepatocyte after binding to CD91
What binds heme released by intravascular hemolysis?
Haptoglobin binds free Hb in circulation - then complex binds to macrophage CD163
Subacute combined degeneration
Refers to neurologic manifestations characteristic of B12 deficiency (sometimes also folate deficiency)
Paresthesias, abnormalities in proprioception - neurologic manifestations predominantly present symmetrically in legs
Radiologic lesions in the posterior/lateral columns of the cervical spinal cord (V sign on MRI)
Chronic non-spherocytic hemolytic anemia
Clues you in to congenital hemolytic anemia due to RBC enzyme deficiencies (i.e. G6PD deficiency)
Episodic jaundice following minor illnesses
Clue to congenital hemolytic anemia - typically membrane protein defects like hereditary spherocytosis or RBC enzyme deficiency like G6PD deficiency
Can also be seen in Gilbert disease (not have hemolytic anemia)